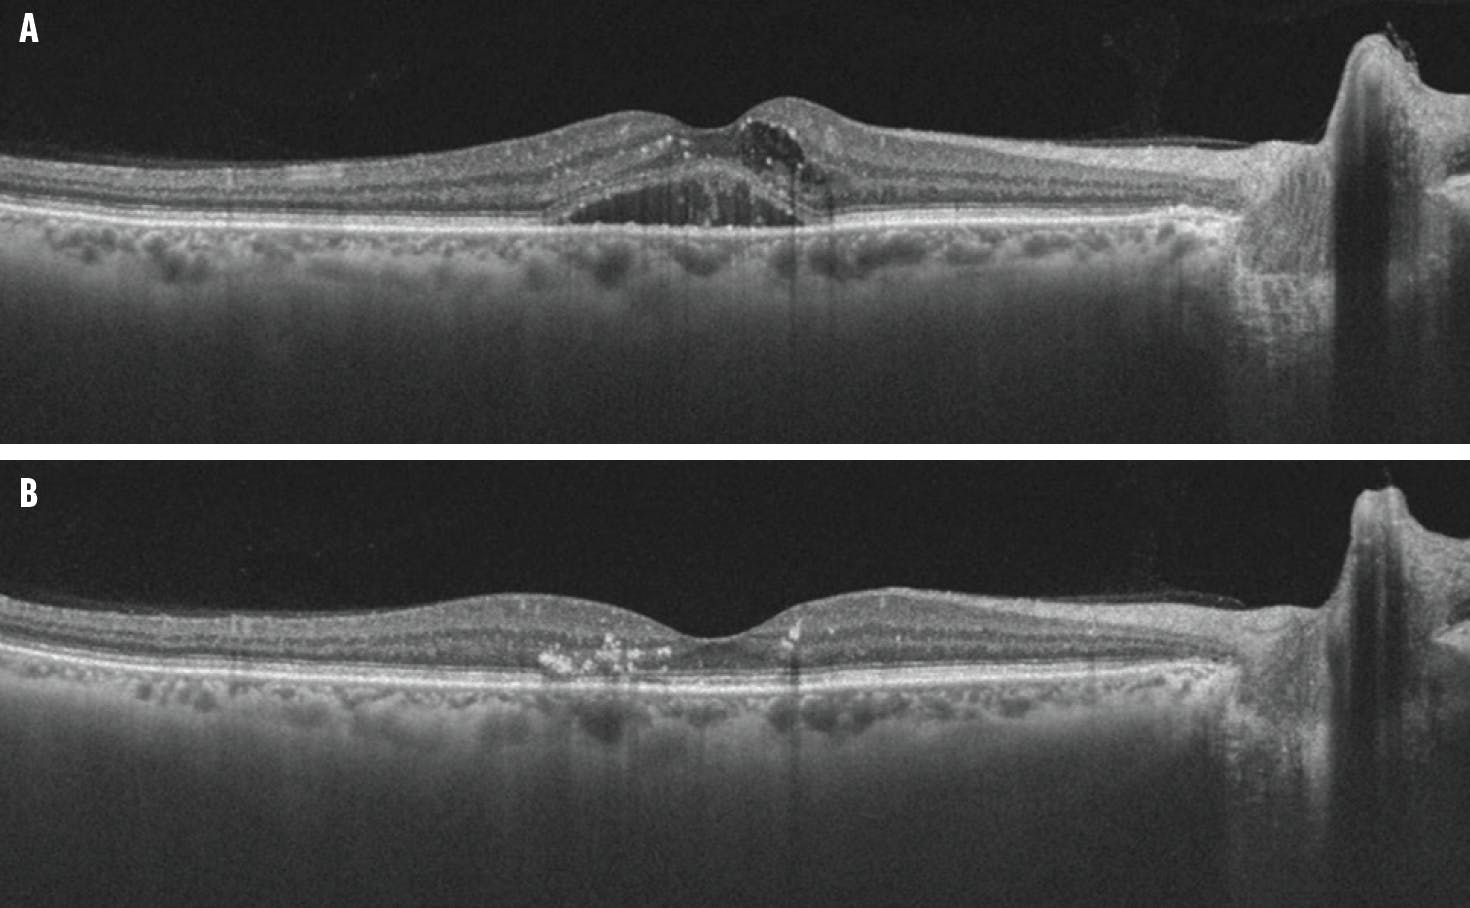
<p>Figure. This patient with persistent DME after initial treatment with 2 mg aflibercept (A) had a dry macula OCT after receiving treatment with faricimab (B).</p>

AT A GLANCE
- A systematic review and meta-analysis assessed the efficacy and safety of combination therapy in patients with diabetic macular edema who are refractory to anti-VEGF treatment.
- The meta-analysis found that combination therapy was associated with a significantly greater reduction in macular thickness; there was no significant difference in the number of injections administered between monotherapy and combination therapy.
- Faricimab (Vabysmo, Genentech/Roche), a combined anti-VEGF and angiopoietin-2 agent, is a novel treatment option for patients with DME who are refractory to anti-VEGF therapy.
Although anti-VEGF agents have become the standard of care for the treatment of diabetic macular edema (DME),1,2 approximately 30% to 40% of patients are refractive to this therapy.3 Thus, alternative treatment approaches are necessary for some patients and can include switching to a different anti-VEGF agent, corticosteroid monotherapy, or combination therapy with anti-VEGF agents and corticosteroid. While intravitreal corticosteroid injections demonstrate similar functional and anatomical results to anti-VEGF treatment, they are associated with increased IOP and cataract development in phakic patients.4 A review of combined anti-VEGF and corticosteroid therapy compared with anti-VEGF monotherapy did not find any significant differences in visual improvement or change in retinal thickness, but combination therapy was associated with an increased rate of IOP- and cataract-related adverse events.5 Despite these findings, the certainty of evidence was low, and, crucially, the review did not assess treatment-refractive populations.
A FOCUS ON REFRACTIVE PATIENTS
We conducted an updated systematic review and meta-analysis to assess the efficacy and safety of combination therapy in anti-VEGF treatment-refractive populations.6 We included randomized controlled trials or observational studies that compared anti-VEGF monotherapy with combined anti-VEGF/steroid therapy for DME refractive to initial anti-VEGF therapy. Importantly, we excluded studies involving a switch from an anti-VEGF agent to steroid monotherapy. The primary outcome was BCVA, and secondary outcomes included change in retinal thickness and adverse events.
We included a total of seven studies: four randomized controlled trials and three observational studies. In terms of visual outcomes, two of the studies found earlier visual improvement with combination therapy; however, none of them found a significant difference in visual acuity with combination therapy relative to monotherapy at the final assessment timepoint.
In addition, combination therapy was associated with significantly greater reductions in macular thickness.
Surprisingly, there was no significant difference in the number of injections administered between the two treatment groups. This is an important finding, as the treatment burden of disease is already high in DME, and this could improve patients’ satisfaction with treatment.7
Not surprisingly, we noted a higher incidence of IOP-related adverse events (P = .002) and cataract-related adverse events (P = .02) with combination therapy.
We also examined the various definitions the studies used to define treatment refractive. There was a substantial amount of heterogeneity among the thresholds each study applied to identify when patients were switched from their initial treatment regimen. Most studies required patients to have a minimum macular thickness between 250 µm to 300 µm and six previous injections before defining them as refractive, although two studies required a minimum of only three injections. Interestingly, less than half of the studies had a visual acuity outcome as part of their criteria for defining patients as treatment refractive.
SWITCHING CONSIDERATIONS
A few key questions remain within the literature surrounding DME patients who are refractive to first-line anti-VEGF treatment, including the following:
- When should a patient be defined as treatment refractive and switched to a new treatment regimen?
- Which treatment regimen should patients be switched to after initial treatment?
Post-hoc analysis from the Diabetic Retinopathy Clinical Research (DRCR) Retina Network Protocol I randomized study found that nearly 40% of patients with DME will have fewer than five letters gained at 3 months of starting anti-VEGF treatment, and of these poor-responding eyes, only 20% to 30% of them will experience clinically significant visual recovery over the next 3 years.3 Similarly, post-hoc analysis of the randomized DRCR Retina Network Protocol T found that, of eyes with less than a five-letter gain at 3 months, only 39% would go on to experience a gain of 10 or more letters at 2 years. The 12-week retinal thickness outcomes were not strongly associated with 2-year outcomes.8
Thus, early response to treatment is a strong prognostic factor for long-term treatment response. It is logical to switch the treatment paradigm immediately once a patient is identified as treatment refractive, as timely elimination of intraretinal and subretinal fluid could prevent additional damage. Retinal thickness has been widely used as a biomarker for response to treatment; however, it may be a relatively unreliable biomarker for long-term functional response. Therefore, it is likely necessary to include vision-related outcomes in definitions of treatment refractive. A recent consensus guideline recommends switching from an initial anti-VEGF treatment if the affected eye shows less than a 20% reduction in central retinal thickness and fewer than five letters gained after three to six injections.9
In terms of choosing the alternative treatment after a patient is deemed refractive to primary anti-VEGF therapy, switching to combination therapy should be approached with caution. Despite the significant anatomical response associated with combination therapy, patients did not see a functional benefit and often experienced the side effects of intravitreal corticosteroids.6 In addition, the increased cost of two simultaneous treatments without strong visual acuity outcomes may be unjustified from a resource stewardship perspective.
Therefore, the chosen treatment approach should be personalized for each patient and will depend on the initial anti-VEGF agent and whether the patient has any ocular comorbidities. The NICE guidelines recommend the use of a fluocinolone acetonide implant (Iluvien, Alimera) for the treatment of chronic DME, irrespective of the phakic status of the eyes.10 A recent meta-analysis of studies examining individuals with persistent DME after anti-VEGF injections showed that switching to a dexamethasone intravitreal implant (Ozurdex, Abbvie) resulted in significant functional and anatomical improvement.11 However, it may be wise to avoid corticosteroids in patients with a history of glaucoma.
Another option is to switch patients to a different anti-VEGF agent, particularly if the patient was started on an older agent. For example, switching from initial bevacizumab (Avastin, Genentech/Roche) or ranibizumab (Lucentis, Genentech/Roche) to 2 mg aflibercept (Eylea, Regeneron) has been demonstrated to improve anatomical and functional responses.12,13 Additionally, 8 mg aflibercept (Eylea HD, Regeneron) presents a promising treatment switch option. An observational study of DME patients with a suboptimal response to initial treatment found that switching from 2 mg to 4 mg aflibercept resulted in a significant reduction in retinal thickness. Thus, 8 mg aflibercept may provide an equally, if not more, efficacious treatment option.14
Faricimab (Vabysmo, Genentech/Roche) is a novel treatment option for patients with DME who are refractory to standard anti-VEGF therapy (Figure).15 One meta-analysis found that faricimab was associated with improved anatomical and functional outcomes compared with bevacizumab, ranibizumab, and aflibercept.16 Furthermore, a recent retrospective study of switching from 2 mg aflibercept to faricimab in treatment-refractive patients found that treatment with faricimab resulted in significantly improved retinal thickness and visual acuity outcomes.17
Figure. This patient with persistent DME after initial treatment with 2 mg aflibercept (A) had a dry macula OCT after receiving treatment with faricimab (B).
Although faricimab and 8 mg aflibercept are intriguing alternative treatment options, the evidence investigating their use for patients with DME who are refractive to anti-VEGF treatment is minimal, and caution should be taken to avoid overgeneralizing the results of small observational studies.
PROCEED WITH CAUTION
Clinicians may identify patients meeting refractory criteria as potential candidates for combination therapy, but they should exercise caution when applying these findings to individual cases. Future research should focus on developing standardized criteria for treatment resistance and directly compare therapeutic alternatives for patients with DME who do not respond to initial treatment.
1. Brown DM, Nguyen QD, Marcus DM, et al. Long-term outcomes of ranibizumab therapy for diabetic macular edema: the 36-month results from two phase III trials: RISE and RIDE. Ophthalmology. 2013;120(10):2013-2022.
2. Tatsumi T. Current treatments for diabetic macular edema. Int J Mol Sci. 2023;24(11):9591.
3. Gonzalez VH, Campbell J, Holekamp NM, et al. Early and long-term responses to anti-vascular endothelial growth factor therapy in diabetic macular edema: analysis of protocol I data. Am J Ophthalmol. 2016;172:72-79.
4. Patil NS, Mihalache A, Hatamnejad A, Popovic MM, Kertes PJ, Muni RH. Intravitreal steroids compared with anti-vegf treatment for diabetic macular edema: a meta-analysis. Ophthalmol Retina. 2023;7(4):289-299.
5. Mehta H, Hennings C, Gillies MC, et al. Anti‐vascular endothelial growth factor combined with intravitreal steroids for diabetic macular oedema. Cochrane Database Syst Rev. 2018;2018(4):CD011599.
6. Hatamnejad A, Orr S, Dadak R, Khanani A, Singh R, Choudhry N. Anti-VEGF and steroid combination therapy relative to anti-VEGF mono therapy for the treatment of refractory DME: A systematic review of efficacy and meta-analysis of safety. Acta Ophthalmologica. 2024;102(3):e204-e214.
7. Gonder JR, Walker VM, Barbeau M, et al. Costs and quality of life in diabetic macular edema: canadian burden of diabetic macular edema observational study (C-REALITY). J Ophthalmol. 2014;2014:939315.
8. Bressler SB, Odia I, Maguire MG, et al. Factors associated with visual acuity and central subfield thickness changes when treating diabetic macular edema with anti-vascular endothelial growth factor therapy: an exploratory analysis of the protocol T randomized clinical trial. Arch Ophthalmol. 2019;137(4):382-389.
9. Downey L, Acharya N, Devonport H, et al. Treatment choices for diabetic macular oedema: a guideline for when to consider an intravitreal corticosteroid, including adaptations for the COVID-19 era. BMJ Open Ophthalmol. 2021;6(1):e000696.
10. Fluocinolone acetonide intravitreal implant for treating chronic diabetic macular oedema. NICE. March 13, 2024. Accessed July 19, 2024. www.nice.org.uk/guidance/ta953/chapter/1-Recommendations
11. Yuan Q, Liu Y, Xu H, et al. Efficacy and safety of single-dose dexamethasone implantation for patients with persistent diabetic macular edema: a systematic review and meta-analysis. Graefes Arch Clin Exp Ophthalmol. 2022;260(2):405-413.
12. Ibrahim WS, Eldaly ZH, Saleh MG, Rateb MF, Aldoghaimy AH. Switching to aflibercept in diabetic macular edema after unsatisfactory response to other anti-vascular endothelial growth factor drugs. Korean J Ophthalmol. 2019;33(2):122-130.
13. Liu Y, Cheng J, Gao Y, Qin L, Min X, Zhang M. Efficacy of switching therapy to aflibercept for patients with persistent diabetic macular edema: a systematic review and meta-analysis. Ann Transl Med. 2020;8(6):382-382.
14. Nielsen J, Roberts C, Saggau D, Alliman K. High-dose aflibercept for neovascular AMD and DME in suboptimal responders to standard-dose aflibercept. J Vitreoretin Dis. 2023;7(2):116-124.
15. Khanani AM, Patel SS, Ferrone PJ, et al. Efficacy of every four monthly and quarterly dosing of faricimab vs ranibizumab in neovascular age-related macular degeneration: the STAIRWAY phase 2 randomized clinical trial. JAMA Ophthalmol. 2020;138(9):964-972.
16. Watkins C, Paulo T, Bührer C, Holekamp NM, Bagijn M. Comparative efficacy, durability and safety of faricimab in the treatment of diabetic macular edema: a systematic literature review and network meta-analysis. Adv Ther. 2023;40(12):5204-5221.
17. Tatsumi T, Kaiho T, Iwase T, et al. treatment effects of switching to faricimab in eyes with diabetic macular edema refractory to aflibercept. Medicina. 2024;60(5):732.












_1773249222.png?auto=compress,format&w=75)










